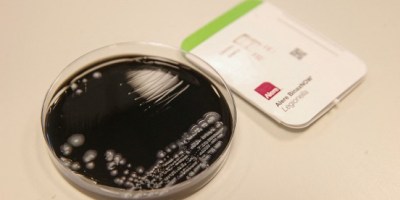

Información de los Estados, Justicia

Entradas 34

Información de los Estados, Justicia

CORONAVIRUS, Información Nacional, salud

Información Internacional, salud

CDMX, Cine y teatro, Espectáculos


Educativas, Información Nacional













IMSS, Información de los Estados


Información de los Estados, seguridad, Seguridad Pública

Estado de México, seguridad, Seguridad Pública


CORONAVIRUS, Estado de México, salud


Deportes, Información Internacional




Educativas, Estado de México, UAEM, UAEMéx

Cámara de Diputados, Guardia Nacional, Información Nacional, SEDENA

